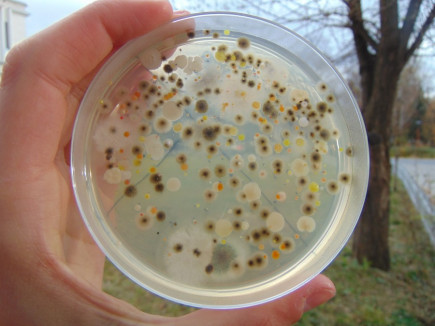
Gyergyószentmiklós levegőjét is bevizsgálták

2016-12-17
Székelyföldi Akadémia Gyergyócsomafalván

2016-12-16
Huszonnégy mentőautót bocsátanak az önkéntes tűzoltók rendelkezésére

2016-12-16
Ott kell lenni mindenhol, hogy legyen beleszólásunk!

Hirdetés
repyx.com - Applikációk, webáruházak és archiváló rendszerek fejlesztése

2016-12-16
Átvehetők a novemberi szociális értékjegyek

2016-12-16
Közel sincs már e vadság erdeinkben a két ünnep között

Hirdetés
repyx.com - Applikációk, webáruházak és archiváló rendszerek fejlesztése

2016-12-15
Indul szurkolóbusz a kupameccsekre is
2016-12-15
Gyergyószentmiklós levegőjét is bevizsgálták

2016-12-15
A Codex Régizene Együttes koncertezik

2016-12-15
Mégsem módosította a román kormány az adótörvényt

2016-12-15
Az RMDSZ-nek 21 képviselője és 9 szenátora lesz a parlamentben

Hirdetés
repyx.com - Applikációk, webáruházak és archiváló rendszerek fejlesztése

2016-12-14
Középdöntőbe jutott a Gyergyói ISK U13-as lánycsapata

2016-12-14
Konyhai cikkek 115.

2016-12-14
A választások utáni első lépések

2016-12-14
Város vs. E-Star

2016-12-13
Öröm és bánat

2016-12-13
„Történelmi sikert ért el a magyar összefogás”

Hirdetés
repyx.com - Applikációk, webáruházak és archiváló rendszerek fejlesztése

2016-12-13
Zenés adventi ifjúsági istentisztelet

Hirdetés
repyx.com - Applikációk, webáruházak és archiváló rendszerek fejlesztése

2016-12-13
